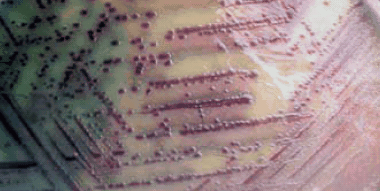
改良HiCrome™ 沙门氏菌琼脂

沙门氏菌分离和鉴定培养基
目前使用经典的培养方法来鉴定沙门氏菌(一种强致病性食源性致病菌)的方法
沙门氏菌污染是全球食源性疾病的第二大成因。控制沙门氏菌的暴发是食品监管机构、餐馆和整个食品工业的一项重要任务。
沙门氏菌家族包括 2,300 多种血清型的细菌,但其中有两种类型,即肠炎沙门氏菌和鼠伤寒沙门氏杆菌,约占所有人类感染的一半。大多数沙门氏菌的暴发可以追溯到乳制品、家禽和肉制品,但沙门氏菌几乎可以在任何食物上生长。鸡、鸡蛋及其衍生产品的风险特别高。

图 1.沙门氏菌
食品工业中的微生物控制在预防沙门氏菌暴发中起着关键作用。用于鉴定沙门氏菌的试验和培养基利用了沙门氏菌在生理学或生物化学上与其他属肠杆菌科不同的独特性质。例如,来自沙门氏菌属的细菌多为兼性厌氧菌、氧化酶阴性、过氧化氢酶阳性和革兰氏阴性杆菌。大多数菌株都能运动并发酵葡萄糖,同时产酸和产气。目前用于区分和鉴定沙门氏菌的培养基仍然基于 pH 指示剂指示的碳水化合物发酵的检测(关于碳水化合物发酵能力,另见表 1 )、蛋白水解活性、硫化氢产量和选择性的检测。大多数现代培养基也结合了一些此类检测系统,使培养基更可靠。最常见的选择性培养基和差异培养基的列表见表 2。
此外,我们目前的技术还可提供显色培养基,可检测到沙门氏菌的一种特征性酶,从而提高鉴定可靠性和速度。这些反应基于导致可见颜色变化的发色底物的裂解(参见表 3)。
图 2.改良HiCrome™ 沙门氏菌琼脂

图 2.1.测试微生物测试微生物

图 3.硫化氢测试条

图 4.基于rRNA检测原理的快速试纸
材料
Loading
登录以继续。
如要继续阅读,请登录或创建帐户。
暂无帐户?